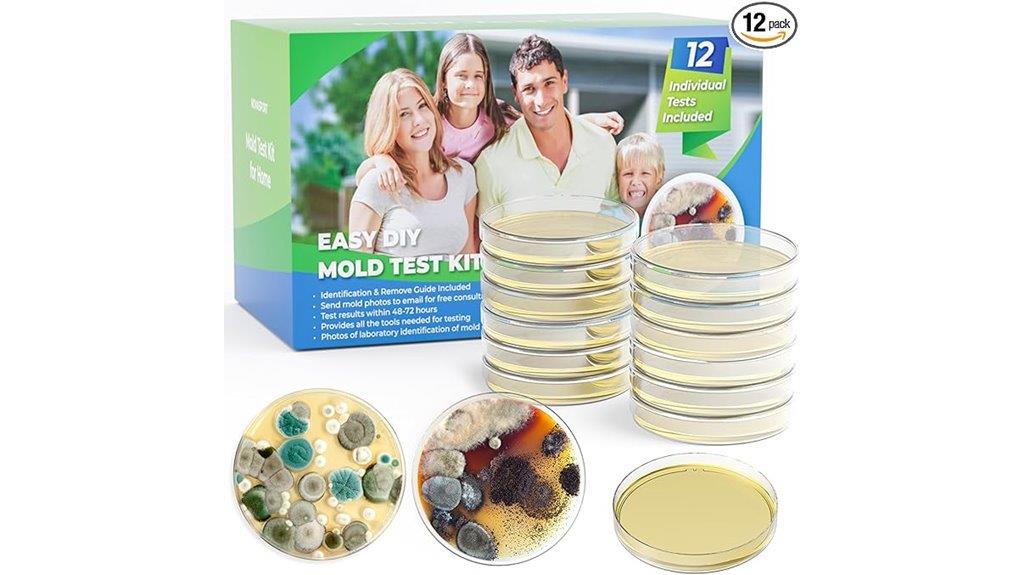
home mold detection kit

Improving indoor air quality is vital for a healthier home environment. I recommend using HEPA air purifiers like the PuroAir 400 and KNKA APH3000 for large spaces. Don’t forget to replace filters regularly and invest in air quality monitors to track pollutants. Also, consider mold testing kits to catch issues early. With simple adjustments, you can breathe easier and feel better. Stick around to discover more tips to enhance your home’s air quality!
Key Takeaways
- Regularly replace air purifier filters every 3–6 months to maintain optimal performance and air quality.
- Utilize air quality monitors to track AQI, CO2, and humidity, adjusting purifiers as needed.
- Incorporate regular cleaning and ventilation practices to reduce indoor pollutants and allergens.
- Place air purifiers strategically in large rooms and high-traffic areas for maximum effectiveness.
- Maintain proper indoor humidity levels to prevent mold growth and ensure a healthier environment.

PuroAir 400 HEPA Air Purifier Large Room Air Cleaner up to 2,000 Ft² - HEPA CarbonTech Filter up to 500X Stronger - Air Quality Sensor, Auto & Quiet Sleep Modes - Air Purifiers for Large Rooms
CLEANER AIR IN MINUTES: PuroAir is proven to filter the pollutants lurking in your home’s air. This large...
As an affiliate, we earn on qualifying purchases.
PuroAir 400 HEPA Air Purifier for Large Rooms

If you’re looking for an air purifier that’s perfect for large spaces, the PuroAir 400 HEPA Air Purifier is a top choice. It covers up to 2,000 square feet, efficiently cleaning the air within just one hour. With its 3-layer filtration system, it captures 99.9% of pollutants like dust, pollen, and pet dander, even filtering particles 700 times smaller than human hair. I appreciate the smart particle sensor that adjusts the fan speed based on air quality and the quiet sleep mode for uninterrupted nights. Plus, it’s backed by a 2-year warranty, ensuring peace of mind for me.
Best For: Those seeking an effective air purification solution for large rooms up to 2,000 sq ft, such as bedrooms and living areas, to combat allergens and pollutants.
Pros:
- 3-layer filtration system captures 99.9% of common pollutants, improving air quality significantly.
- Smart particle sensor automatically adjusts fan speed for optimal performance based on air quality.
- Quiet operation with sleep mode ensures minimal disruption during nighttime use.
Cons:
- Initial cost may be higher compared to basic air purifiers.
- Requires regular filter replacements to maintain effectiveness, which can add to long-term costs.
- May be too large for small rooms, making it less versatile in smaller spaces.

KNKA Air Purifiers for Home Large Room Bedroom Up to 1123 Ft² in 1 Hr, Washable Filters, AQI Display, Turbo & Auto Modes, HEPA Sleep Mode, Air Cleaner for Dust, Pet Hair, Pollen (APH3000)
𝐄𝐟𝐟𝐨𝐫𝐭𝐥𝐞𝐬𝐬𝐥𝐲 𝐏𝐮𝐫𝐢𝐟𝐢𝐞𝐬 𝐔𝐩 𝐭𝐨 𝟏𝟏𝟐𝟑 𝐟𝐭²: KNKA air purifier is ideal for bedrooms, living rooms, offices, and large...
As an affiliate, we earn on qualifying purchases.
KNKA Air Purifier for Large Rooms (APH3000)

For anyone looking to improve air quality in large spaces, the KNKA Air Purifier (APH3000) is an excellent choice that covers up to 2,325 square feet. Its advanced triple filtration system, featuring HEPA H13 filters, removes 99.9% of particles like dust and pet dander. I appreciate the sleek design, adjustable lights, and a convenient child lock. The built-in sensor monitors air quality, while the Turbo Mode speeds up purification. Plus, with an ultra-quiet Sleep Mode at 24dB, it guarantees restful nights. This purifier is perfect for my home, especially with pets and allergy concerns.
Best For: Those seeking an effective air purification solution for large rooms, especially pet owners and allergy sufferers.
Pros:
- Advanced triple filtration system effectively removes 99.9% of harmful particles, improving air quality.
- Ultra-quiet Sleep Mode at 24dB ensures minimal disturbance during rest.
- User-friendly features like adjustable lights, child lock, and air quality monitoring enhance convenience and safety.
Cons:
- Filter replacement needed every 3–6 months, which may incur additional costs.
- Large size may not be suitable for smaller spaces or apartments.
- Turbo Mode may consume more energy, potentially affecting electricity bills.

EVALIT Air Purifiers for Home Large Room, Air Purifier up to 2200sq.ft, PM2.5 Air Quality Display, Sleep Mode with Fragrance for Smoke Dust Odors, ET066, White, 1Pack+3Modes
Covers Up To 2200 ft² for Large Rooms: Specifically designed for spacious areas, this home air purifier effectively...
As an affiliate, we earn on qualifying purchases.
EVALIT Air Purifier for Home (2200 sq.ft, Washable Filters)

The EVALIT Air Purifier is perfect for anyone living in spacious homes or open environments, as it effectively covers areas up to 2,200 sq.ft. I love its three-stage filtration system that captures even the tiniest particles, like pollen and smoke. The washable pre-filter is a game-changer, saving me money on replacements. If you have pets, the special mode tackles dander and odors effortlessly. Plus, the aromatherapy compartment lets me enjoy calming scents while cleaning the air. With smart features like real-time air quality monitoring and a child-lock for safety, it’s truly a versatile addition to my home.
Best For: Families and pet owners living in spacious homes who want to maintain a healthy indoor air quality.
Pros:
- Three-stage filtration effectively captures particles as small as 0.3 microns, improving air quality.
- Washable pre-filter reduces replacement costs and waste, making it economical and environmentally friendly.
- Aromatherapy compartment allows users to enjoy pleasant scents while purifying the air.
Cons:
- Size and weight may make it cumbersome to move between rooms.
- Initial cost might be higher compared to smaller air purifiers.
- Noise level on high fan speed may be disruptive in quiet environments.
Amazon Product B09S2W8VBB
As an affiliate, we earn on qualifying purchases.
AROEVE Air Purifier for Home (MK04)

Looking to breathe easier at home? The AROVE Air Purifier (MK04) has been a game changer for me. It cleans rooms up to 1,095 sq ft every hour, ensuring I’m surrounded by fresh air. Its built-in PM2.5 sensor keeps me informed about air quality, adjusting the fan speed automatically when needed. I love that it operates quietly in sleep mode, letting me rest without disruption. Plus, changing the filter is a breeze! With its user-friendly design and reliable performance, this purifier has made my living space healthier and more comfortable. I highly recommend it for anyone seeking cleaner air.
Best For: Those seeking an effective air purification solution for large spaces and a healthier living environment.
Pros:
- Impressive coverage: Cleans rooms up to 1,095 sq ft every hour, ensuring fresh air in large areas.
- Automatic air quality monitoring: Built-in PM2.5 sensor adjusts fan speed based on pollution levels for optimal air quality.
- Quiet operation: Sleep mode allows for low noise levels, making it ideal for bedrooms and quiet environments.
Cons:
- Filter replacement frequency: Requires filter changes every 3-6 months, which may be inconvenient for some users.
- Dependence on official filters: Optimal performance is only guaranteed with official filters, limiting options for replacements.
- Potentially higher initial cost: The price point may be higher than some basic air purifiers on the market.
Air Purifier for Home Large Room with HEPA Filter

Choosing an air purifier with a HEPA filter can be a game changer if you want to breathe cleaner air in large spaces. I love the LUNINO air purifier for its dual-sided air intake, which speeds up purification by 40%. It covers up to 2,600 sq ft while consuming only 18W, making it perfect for my living room or home office. With a 3-stage filtration system, it captures 99.97% of allergens. Plus, I appreciate the smart control features that let me monitor air quality in real-time. It’s quiet, efficient, and really enhances my home’s air quality.
Best For: Those seeking an efficient and compact air purifier for large spaces, such as living rooms and home offices, that offers smart features and high filtration performance.
Pros:
- Dual-sided air intake design for 40% faster purification.
- Covers large areas up to 2,600 sq ft while consuming only 18W.
- Smart control features with real-time air quality monitoring and automation.
Cons:
- Requires monthly maintenance for the washable pre-filter.
- Official filter replacements may incur additional costs over time.
- Some users might find the initial setup of the app and smart features complex.
Air Quality Monitor Indoor, 8-in-1 Smart Air Quality Tester

For anyone concerned about indoor air quality, the 8-in-1 Smart Air Quality Tester is an excellent choice. This compact device measures vital factors like AQI, CO2, HCHO, TVOC, temperature, and humidity with impressive accuracy. I love its large, colorful screen that displays five data types at once, making it easy to understand my environment at a glance. Plus, the battery lasts 9-10 hours with quick charging via Type-C. The alarm function alerts me to any unsafe levels, ensuring I stay informed. It’s perfect for continuous monitoring in my home, office, or even my car.
Best For: Individuals and families who want to monitor and improve their indoor air quality for a healthier living environment.
Pros:
- Accurate Measurements: Provides precise readings of AQI, CO2, HCHO, TVOC, temperature, and humidity.
- User-Friendly Display: Large, colorful screen with simultaneous display of multiple data types for easy interpretation.
- Portable and Convenient: Compact design with a long-lasting battery allows for easy transport and continuous monitoring.
Cons:
- Limited Battery Life: While it lasts 9-10 hours, it may require frequent recharging for continuous use.
- Potential Sensitivity: High-performance chip may be sensitive to environmental factors, affecting measurement accuracy in certain conditions.
- Price Point: May be considered expensive compared to basic air quality monitors on the market.
DAYETTE HEPA 14 Air Purifier for Large Rooms

If you want to guarantee your large living spaces stay fresh and free of pollutants, the DAYETTE HEPA 14 Air Purifier is an excellent choice. It covers up to 2,200 square feet in just an hour, making it perfect for living rooms, kitchens, and even whole houses. With its advanced HEPA H14 filter, it captures 99.997% of airborne particles, including dust and pet dander. I love the built-in PM2.5 sensor that adjusts the fan speed based on air quality. Plus, it operates quietly, allowing for undisturbed sleep. This purifier blends seamlessly into my home decor while ensuring cleaner, healthier air.
Best For: Those seeking an effective air purification solution for large spaces such as living rooms, kitchens, and whole houses.
Pros:
- Covers a large area: Purifies up to 2,200 square feet in one hour, making it ideal for expansive spaces.
- Highly effective filtration: The HEPA H14 filter captures 99.997% of airborne particles, ensuring cleaner air.
- Quiet operation: Features a sleep mode that operates at just 22 dB, perfect for undisturbed sleep.
Cons:
- Initial cost: The upfront price may be higher compared to smaller air purifiers.
- Filter replacement costs: Replacement filters can add to long-term maintenance expenses.
- Size and weight: Its size may not be suitable for smaller rooms or spaces with limited floor area.
18-in-1 Smart Air Quality Monitor

The 18-in-1 Smart Air Quality Monitor is perfect for anyone who wants to take control of their indoor environment and guarantee a healthier home. With its advanced dual-chip technology, it provides precise readings for pollutants like CO2, PM2.5, and TVOC. I love the HD LCD display and color-coded alerts that make monitoring easy. Plus, the Smart Life app keeps me updated on air quality trends, even when I’m away. The rechargeable battery lasts up to 15 hours, ensuring continuous monitoring. Whether at home or outdoors, this device empowers me to create a safe, healthy space for my family and myself.
Best For: Individuals and families seeking to monitor and improve their indoor air quality for a healthier living environment.
Pros:
- Comprehensive Monitoring: Detects multiple pollutants including CO2, PM2.5, and TVOC for thorough air quality assessment.
- User-Friendly Interface: Features an HD LCD display with color-coded alerts and intuitive app integration for easy tracking and management.
- Long Battery Life: The rechargeable battery lasts up to 15 hours, allowing for continuous monitoring without the need for constant recharging.
Cons:
- Wi-Fi Dependency: Requires a stable Wi-Fi connection for full functionality, which may be a limitation in certain areas.
- Calibration Needs: May require periodic calibration for accuracy, especially if readings become inconsistent.
- Size and Portability: While suitable for various settings, its design may not be as compact for easy transport compared to simpler air quality monitors.
EVALIT Air Purifier for Large Rooms (up to 2200 sq.ft)

Looking to improve air quality in spacious areas? The EVALIT Air Purifier is perfect for rooms up to 2,200 sq.ft. Its three-stage filtration system captures pesky particles like pollen, dust, and pet dander, making it a great choice for pet owners. I love the washable pre-filter that saves me money and reduces waste. Plus, it has a dedicated compartment for essential oils, combining purification with aromatherapy. With smart features like a PM2.5 sensor and auto mode, it adjusts to my home’s air quality effortlessly. It’s quiet, customizable, and even includes a child-lock for safety—perfect for families!
Best For: Families and pet owners looking to improve indoor air quality in large spaces.
Pros:
- Three-stage filtration system effectively captures allergens, smoke, and odors, ensuring cleaner air.
- Aromatherapy compartment allows users to add essential oils for a more pleasant ambiance.
- Smart features like PM2.5 sensor and auto mode provide real-time air quality monitoring and energy-efficient operation.
Cons:
- May be too large for small rooms, making it less versatile for smaller living spaces.
- Initial cost may be higher compared to basic air purifiers.
- Some users may find the noise level noticeable at higher fan speeds.
WINIX AM90 Air Purifier for Large Rooms

For anyone seeking to maintain a healthier living space, the WINIX AM90 Air Purifier stands out as an exceptional choice, especially for those with large rooms. It efficiently covers up to 1,740 square feet in just one hour, ensuring clean air in no time. With a powerful 4-stage purification system, it captures 99.99% of airborne particles, from dust to pet dander. I love the real-time air quality indicators and smart features, which allow me to monitor everything through the Winix Smart App. Plus, the sleep mode operates quietly at just 27 decibels, making it perfect for nighttime use.
Best For: Those seeking a high-performance air purifier for large spaces to improve indoor air quality and reduce allergens.
Pros:
- Effective filtration: Removes 99.99% of airborne particles, including allergens as small as 0.01 microns.
- Smart features: WiFi connectivity and the Winix Smart App allow for remote monitoring and control.
- Quiet operation: Sleep mode operates at a low noise level of just 27 decibels, ideal for nighttime use.
Cons:
- Size and weight: At 16.5 pounds, it may be less portable compared to smaller models.
- Annual filter replacement: Requires changing filters every 12 months, which may add to maintenance costs.
- Price: Higher upfront cost compared to basic air purifiers, which may not fit all budgets.
MORENTO Air Purifier for Large Rooms

Experience the difference with the MORENTO Air Purifier, especially designed for large rooms up to 1,076 square feet. I love how it fits perfectly in my living room, ensuring fresh air in open spaces. With a CADR of up to 300 m³/h, it refreshes the air every hour. The dual side air intake boosts purification efficiency, while the infrared PM 2.5 sensor keeps me informed of air quality. Plus, it operates quietly at under 24 dB during sleep mode, making it ideal for bedrooms. With adjustable fan speeds and a timer, it’s easy to customize my air quality experience.
Best For: Individuals seeking effective air purification solutions for large living spaces, such as bedrooms and open areas, while maintaining a quiet environment.
Pros:
- Efficiently covers large rooms up to 1,076 sq ft with a high CADR of 300 m³/h.
- Features real-time air quality monitoring with an infrared PM 2.5 sensor.
- Operates quietly in sleep mode, making it suitable for nighttime use.
Cons:
- Initial cost may be higher compared to smaller air purifiers.
- Requires regular replacement of filters to maintain efficiency.
- Some users may find the size cumbersome for smaller spaces.
Smart Air Quality Monitor (18-in-1)

If you want to take charge of your indoor air quality, the 18-in-1 Smart Air Quality Monitor by Bcetasy is an excellent choice. This device measures everything from AQI and CO2 to PM2.5 and humidity, giving you a detailed view of your home’s air quality. Its HD LCD screen offers color-coded alerts, making it easy to understand your data at a glance. With Wi-Fi connectivity, I can monitor air quality remotely through the Smart Life app. Plus, the skin-friendly surface and energy-efficient battery ensure it fits seamlessly into my home while keeping my family safe from airborne pollutants.
Best For: Individuals and families looking to monitor and improve their indoor air quality for better health and well-being.
Pros:
- Comprehensive detection of multiple air quality metrics including AQI, CO2, PM2.5, and humidity.
- Wi-Fi connectivity allows for remote monitoring and data analysis through the Smart Life app.
- Energy-efficient design with a long-lasting battery for flexible usage.
Cons:
- Requires regular recalibration for optimal sensor accuracy, which may be inconvenient.
- Dependency on Wi-Fi connectivity could limit functionality in areas with poor internet service.
- Initial setup may require some technical knowledge for optimal use.
Mold Test Kit for Home – 12 PCS DIY Mold Detector
Homeowners concerned about indoor air quality will find the Mold Test Kit for Home – 12 PCS DIY Mold Detector to be an invaluable tool. This thorough kit includes everything you need, from 12 test panels to gloves and a detailed mold identification guide. I love how easy it is to use; just follow the clear instructions to identify potential mold issues in your home. Plus, the air quality tester helps detect airborne spores, which is vital for allergy sufferers. Regularly using this kit can prevent health problems and guarantee a safe living environment. Don’t wait; take control of your home’s air quality today!
Best For: Homeowners concerned about indoor air quality and those wanting to proactively manage mold issues in their living spaces.
Pros:
- Comprehensive kit includes all necessary tools for thorough mold detection and identification.
- User-friendly design makes it easy for anyone to conduct tests without prior experience.
- Supports health maintenance by facilitating early detection of mold, reducing the risk of respiratory illnesses.
Cons:
- Requires time and effort to conduct tests and analyze results, which may be inconvenient for some users.
- Limited to DIY testing, so professional assistance may still be needed for severe mold issues.
- Does not guarantee complete mold removal, as it primarily focuses on detection rather than remediation.
Air Quality Monitor for Indoor Pollution Detection

For anyone concerned about indoor air quality, an Air Quality Monitor is an invaluable tool. I use mine to detect indoor pollutants like formaldehyde and total volatile organic compounds (TVOC). With its sensitive sensors and the SEN+ algorithm, I get accurate readings quickly. The large LCD screen and one-button operation make it user-friendly, while the three-color warning light helps me easily assess pollution levels. It’s perfect for monitoring air quality in any room of my home. By tracking these levels, I can take timely action to ensure a healthier environment for myself and my family.
Best For: Individuals and families looking to monitor and improve indoor air quality in their homes or workplaces.
Pros:
- Accurate and fast detection of formaldehyde and TVOC levels with sensitive sensors and SEN+ algorithm.
- User-friendly design with a large LCD screen and one-button operation for easy use.
- Visual pollution level indicators (three-color warning light) make it simple to assess air quality at a glance.
Cons:
- Limited to indoor use; may not provide accurate readings if doors and windows are open during testing.
- Requires regular calibration to maintain accuracy, which may be inconvenient for some users.
- The initial cost may be a consideration for those on a tight budget.
Smart Air Quality Monitor – Indoor WiFi Detector

Having a reliable tool to monitor indoor air quality is essential, especially for anyone concerned about health and wellness. The Bcetasy Smart Air Quality Monitor impresses me with its 18-in-1 capabilities, detecting everything from AQI to CO2 levels. I appreciate the real-time data display and alarm notifications, which keep me informed of any significant changes. Connecting via Wi-Fi to the Smart Life app allows me to track trends and manage settings remotely. With its dual-chip technology, accuracy is spot-on. Plus, its user-friendly design makes it easy to set up and maintain, ensuring a healthier environment at home or on the go.
Best For: Individuals and families who prioritize health and wellness by monitoring indoor air quality for pollutants and allergens.
Pros:
- Real-time data display and alarm notifications keep users informed of air quality changes.
- Dual-chip technology ensures high accuracy in measurements and enhances user experience.
- Wi-Fi connectivity with app integration allows for remote monitoring and trend tracking.
Cons:
- Limited to 2.4GHz Wi-Fi connectivity, which may not suit all home networks.
- Battery life may be insufficient for extended use without frequent recharging.
- Initial setup may require a learning curve for users unfamiliar with smart devices.
Factors to Consider When Choosing Air‑Quality Improvement

When choosing an air-quality improvement solution, I consider several key factors that can really make a difference. Room size, the type of filtration system, and noise level preferences all play a role in my decision. Plus, I always weigh the availability of smart features and maintenance costs to guarantee I’m making the best choice for my home.
Room Size Consideration
Choosing the right air purifier can feel overwhelming, especially with so many options available. One critical factor I always consider is room size. It’s vital to pick an air purifier with a coverage area that matches or exceeds my room size for effective air cleaning. For larger spaces, like living rooms, I opt for purifiers with higher CADR ratings and better airflow capacity. If my room is over 1,000 square feet, I make sure the model can filter the entire area within an hour for timely results. I’ve learned that smaller units often struggle in larger spaces, leading to limited pollutant removal. So, I always double-check the recommended room size to guarantee optimal performance and energy efficiency.
Filtration System Type
Understanding the different types of filtration systems can substantially impact the air quality in my home. I often consider HEPA filters, which capture at least 99.97% of airborne particles, including dust and pet dander. For eliminating odors and gaseous pollutants, activated carbon filters are incredibly effective, enhancing overall freshness. I also appreciate washable pre-filters, as they extend the lifespan of main filters while reducing maintenance costs, making them a more sustainable choice. Some systems combine HEPA, activated carbon, and pre-filters, tackling a wide range of airborne contaminants. I always check for independent testing and certifications to verify the system I choose reliably removes pollutants, giving me peace of mind about the air I breathe.
Noise Level Preferences
As I navigate the various options for air purifiers, the noise level is a crucial factor I can’t overlook. I’ve learned that noise levels are measured in decibels (dB), with quieter models operating below 30 dB, perfect for my peaceful indoor environment. For my bedroom or office, I prefer purifiers with sleep modes that reduce noise to as low as 15-22 dB, ensuring minimal disturbance during rest. I’ve noticed that higher fan speeds can exceed 50 dB, which would be disruptive in quiet spaces. Ultimately, my noise level preference might differ from yours; while I prioritize silent operation, some might accept moderate noise for quicker purification. It’s essential to find what works best for my comfort.
Smart Features Availability
What smart features should I look for in an air purifier to enhance my home’s air quality? First, I’d recommend checking for smart sensors that automatically adjust the fan speed based on real-time air quality data. This guarantees ideal performance without my constant input. Next, I find app connectivity essential for remote monitoring and control, allowing me to track air quality metrics easily. Features like auto mode are also great, as they maintain air quality effortlessly. Real-time visual indicators, such as LED color codes or digital displays, help me quickly interpret air conditions. Lastly, customizable alerts and notifications keep me informed about pollution levels and the device’s performance, making it easier to breathe clean air in my home.
Maintenance and Cost
Choosing the right air purifier goes beyond just initial purchase price; it’s important to contemplate the ongoing maintenance and associated costs. Regularly replacing filters, like HEPA or activated carbon, is essential for efficiency and can cost between $20 and $80 each. Some devices feature washable pre-filters, which can help reduce expenses. Don’t forget about potential replacement parts, such as UV bulbs or sensors, ranging from $10 to $50. Also, consider energy consumption; energy-efficient models can save you money on electricity bills over time. By monitoring device lifespan and filter replacement schedules, I can avoid unexpected costs and ensure effective air quality improvement in my home.
Air Quality Monitoring
How can I effectively monitor the air quality in my home? First, I choose a sensor that detects multiple pollutants like PM2.5, CO2, VOCs, and formaldehyde with high accuracy. I prefer devices that display real-time data with color-coded indicators, making it easy to assess conditions at a glance. It’s also essential for me to have integration with smartphone apps or smart home systems, allowing remote monitoring and trend analysis. I appreciate alarms and notifications that alert me when air quality dips, so I can act quickly. Finally, I remember that regular calibration and maintenance of these sensors are vital for accurate and reliable measurements. With these factors in mind, I can ensure a healthier home environment.
Frequently Asked Questions
How Often Should I Replace the Filters in My Air Purifier?
I typically replace the filters in my air purifier every three to six months, depending on usage and air quality. If I notice increased dust or a reduction in airflow, I change them sooner. It’s essential to check the manufacturer’s guidelines for specific recommendations. Keeping my filters clean not only helps maintain efficiency but also ensures I’m breathing the best air possible in my home. Don’t forget to keep an eye on them!
Can Air Purifiers Eliminate Odors Completely?
Air purifiers can considerably reduce odors, but they can’t eliminate them completely. I’ve noticed that while my air purifier tackles common smells like pet odors and cooking scents, some stubborn odors linger. It’s like trying to catch smoke with your hands; you can minimize it, but it won’t be gone entirely. To get the best results, I combine my air purifier with proper ventilation and regular cleaning to create a fresher environment.
What Is the Ideal Humidity Level for Indoor Air Quality?
I’ve found that the ideal indoor humidity level is between 30% and 50%. Keeping it in this range not only helps me feel comfortable but also prevents mold growth and dust mites. If it’s too high, I notice musty odors and respiratory issues, while too low can lead to dry skin and irritated sinuses. I use a hygrometer to monitor levels and adjust with a humidifier or dehumidifier as needed.
Do Plants Improve Indoor Air Quality Effectively?
Yes, I believe plants can effectively improve indoor air quality. I’ve noticed that having a few houseplants in my home not only adds beauty but also helps filter out toxins and increase oxygen levels. Plants like spider plants and peace lilies are particularly good at this. Plus, taking care of them brings me joy and a sense of connection to nature. So, if you haven’t already, consider adding some greenery to your space!
How Can I Test for Indoor Air Pollutants?
I recently wanted to check for indoor air pollutants, so I bought an air quality monitor. It’s a simple device that tracks levels of VOCs, dust, and other harmful particles. After setting it up in my living room, I noticed high readings near my old carpet. I opened windows and vacuumed regularly, which helped lower the pollutants. If you want to test your air, I recommend using a reliable monitor to get accurate results.
Conclusion
In summary, improving your home’s air quality can make a significant difference in your overall health and well-being. Did you know that indoor air can be up to five times more polluted than outdoor air? By using air purifiers, monitoring pollution levels, and addressing mold, you can create a cleaner, healthier environment for yourself and your loved ones. So, take action today—your lungs will thank you for it!